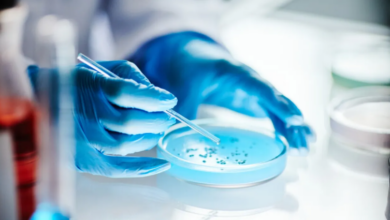

-
أخبار العالم

تفشي التهاب السحايا في كانتربري يسفر عن وفاة شخصين ونقل 11 شابًا إلى المستشفى
عرب لندن شهدت مدينة كانتربري، الواقعة في جنوب شرق إنجلترا، وفاة طالب من جامعة كنت وشخص آخر بسبب تفشي حالات…
أكمل القراءة » -
أخبار الفن

ريم مصطفى تنجح فى تحليل فريق يوسف الشريف بمسلسل فن الحرب
تصاعدت وتيرة الحرب والمؤامرات بين ياسمين النشرتي التي تؤدي دورها ريم مصطفى، وزياد الذي يجسده يوسف الشريف، خلال الحلقة الـ26…
أكمل القراءة » -
أخبار الفن

مسلسل علي كلاي الحلقة 26.. عزازي يطلب استعادة علي إلى التوفيقية
شهدت الحلقة السادسة والعشرون من مسلسل علي كلاي مواجهة بين عزازي (محمود البزاوي) وعلي كلاي (أحمد العوضي)، حيث طلب…
أكمل القراءة » -
أخبار الفن

مسلسل على قدر الحب الحلقة 26.. محامى نيللى كريم يفجر مفاجأة حول الماركة.. مراد يهدد محاميه بسبب ملكية التصميمات.. كريم لوى دراع مراد وثبت عليه تهم بضربة معلم.. ووالدة سارة تتبرأ منها وتطردها من المنزل
شهدت الحلقة الـ26 من مسلسل «على قد الحب» تطورات جديدة في الصراع القانوني حول ملكية العلامة التجارية والتصميمات الخاصة…
أكمل القراءة » -
أخبار الفن

“الأعلى للإعلام” عن مسلسل “اللون الأزرق”: يناقش قضية كبيرة
وصف المجلس الأعلى للإعلام مسلسل “اللون الأزرق” الذي يضم النجمين جومانا مراد وأحمد رزق، بأنه عمل مميز ضمن مسلسلات رمضان…
أكمل القراءة » -
أخبار الفن

«تعاطي الأيس يغير مجرى الأحداث في مسلسل أب مع اعتراف أدهم لنادية»
جاءت الحلقة الحادية عشرة من مسلسل “أب ولكن”، الذي يقوم ببطولته محمد فراج وهاجر أحمد وركين سعد، لتشهد اعتراف…
أكمل القراءة » -
أخبار العالم

العوامل التي تجعل النساء أكثر عرضة للإصابة بالسرطان مقارنة بالرجال
تستمر معدلات الإصابة بالسرطان في الارتفاع للعديد من الأنواع الشائعة، ولا سيما بين النساء. في الفترة من عام 2002 إلى…
أكمل القراءة » -
أخبار العالم

تناول الدهون الصحية يعزز فعالية التمارين لمرضى السكري
تعتبر ممارسة الرياضة من الأدوات الأساسية للحفاظ على الصحة العامة وتعزيز اللياقة البدنية، لكن قد يواجه بعض الأشخاص، خصوصاً أولئك…
أكمل القراءة » -
أخبار العالم

اكتشاف آلية جديدة تُحدث ثورة في فهم العقم وتؤثر على البلوغ والخصوبة
أعلن علماء إسبان عن اكتشاف مثير يكشف أن خلايا مناعية تتواجد في الدماغ تلعب دورًا رئيسيًا في تنظيم خصوبة الإنسان،…
أكمل القراءة » -
أخبار العالم

زيادة ملحوظة في حالات الإصابة بالنكاف في أمريكا وأهم العلامات ونصائح للوقاية
شهدت الولايات المتحدة زيادة ملحوظة في حالات الإصابة بالنكاف، وهو فيروس مُعدٍ يُنقل عبر الرذاذ التنفسي والتواصل المباشر مع الأشخاص…
أكمل القراءة » -
أخبار العالم

دراما فرصة أخيرة تكشف عن مخاطر كسر الجمجمة وكيفية علاجه
في الحلقة العاشرة من مسلسل “فرصة أخيرة”، شهدنا تصعيداً درامياً مكثفاً بعد تعرض الطفلة فيروز، حفيدة يحيى الأسواني، لإصابة خطيرة…
أكمل القراءة » -
أخبار العالم

مبرمج يستخدم تشات جي بي تي لتطوير لقاح مبتكر ينقذ كلبته من مرض السرطان
في مظهرٍ يبدو وكأنه مقتبس من روايات الخيال العلمي، تحوّلت حكاية الأسترالي بول كونينغهام وكلبته روزي إلى رمزٍ عالمي يجسد…
أكمل القراءة » -
أخبار العالم

رحلة المذنب C/2026 A1 حول الشمس تكشف أسرار جديدة وفقاً لخبير فلكي
يُظهر الباحثون في معهد بحوث الفضاء التابع لأكاديمية العلوم الروسية أن المذنب المعروف باسم “C/2026 A1” سيظل في النظام الشمسي،…
أكمل القراءة » -
أخبار العالم

جمعية القلب الأمريكية تطلق إرشادات حديثة لفحص مستويات الكوليسترول بين الشباب
أصدرت جمعية القلب الأمريكية توصيات جديدة تتعلق بفحص وعلاج الأشخاص في الثلاثينيات من أعمارهم، حيث تشير الدراسات إلى أن مخاطر…
أكمل القراءة » -
أخبار العالم

إرشادات جمعية القلب الأمريكية الجديدة تشير إلى أهمية الوقاية من أمراض القلب منذ الصغر
أوصت جمعية القلب الأمريكية بتحديث طريقة تقييم وعلاج اضطرابات الدهون في الدم، في مسعى للتركيز على الوقاية المبكرة من أمراض…
أكمل القراءة » -
أخبار العالم

فوائد الصيام الليلي في تحسين ضغط الدم ومستوى السكر في الجسم
أظهرت دراسة حديثة أن الصيام الليلي لمدة تصل إلى 12 ساعة، مع الامتناع عن تناول الطعام قبل النوم بثلاث ساعات،…
أكمل القراءة » -
أخبار العالم

طرق فعالة لتناول الخضراوات الغنية بالحديد والاستفادة القصوى منها
يعتبر الحديد من العناصر المعدنية الحيوية الضرورية لصحة الجسم، حيث يلعب دورًا أساسيًا في تكوين الهيموجلوبين الذي ينقل الأكسجين إلى…
أكمل القراءة » -
أخبار العالم

تعزيز التواصل بين الأفراد: كيف تبني علاقات فعالة في عالم متصل
السمنة ليست مجرد مشكلة تتعلق بالمظهر أو نمط الحياة، بل هي مرض مزمن ومعقد يرتبط باضطرابات التمثيل الغذائي، مما يستدعي…
أكمل القراءة » -
أخبار العالم
اكتشاف جديد يغير مفهوم العقم ويربط بين آلية البلوغ والخصوبة
أظهرت دراسة حديثة أن خلايا المناعة في الدماغ تلعب دورًا أساسيًا في تنظيم الخصوبة، مما قد يمهد الطريق لعلاجات جديدة…
أكمل القراءة » -
أخبار العالم

أفضل مصادر طبيعية للحصول على الألياف بدون استخدام المكملات الغذائية
تعد الألياف الغذائية عنصرًا حيويًا لصحة الجهاز الهضمي، حيث تسهم في تعزيز وظيفة الأمعاء وتنظيم حركتها، كما تلعب دورًا هامًا…
أكمل القراءة » -
أخبار العالم

ابتكار يتوقع أن يُحدث تحولاً في جراحة ترميم العظام
متابعة – واع ابتكر باحثون في المعهد الفدرالي السويسري للتكنولوجيا بلوزان مادة تشبه العظام تسهم في ترميمها بسرعة وكفاءة أعلى.…
أكمل القراءة » -
أخبار العالم

مكمل غذائي من شجرة عريقة يثير جدلاً واسعًا بشأن فوائده في combating الالتهابات والسرطان
أظهرت الأبحاث الحديثة أن مستخلصًا معينًا من راتنج شجرة غير معروفة على نطاق واسع، والتي تنمو في الهند وإفريقيا والشرق…
أكمل القراءة » -
أخبار العالم

نجاة المولود من الجراثيم منذ اللحظة الأولى مفاجآت مثيرة في عالم الحمل
يستقبل الطفل في اللحظات الأولى من حياته عالمًا مليئًا بالكائنات الدقيقة، حيث تتواجد البكتيريا في كل مكان، من الهواء إلى…
أكمل القراءة » -
أخبار العالم

أطعمة فعالة تساهم في تقليل خطر الإصابة بسرطان القولون
عمان جو- مع تزايد الوعي بالصحة الوقائية، يزداد التركيز على دور التغذية في تقليل مخاطر الإصابة بأنواع معينة من السرطان،…
أكمل القراءة »